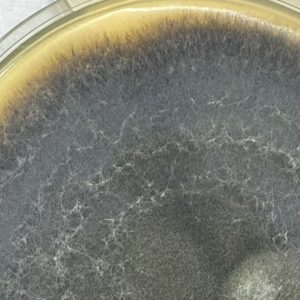

新月弯孢霉(Curvularia lunata)
隶属于半知菌亚门(Deuteromycotina)、丝孢纲(Hyphomycetes)、暗色孢菌科(Dematiaceae),是一种常见的暗色丝状真菌。该菌广泛分布于土壤、植物残体及空气中,属于典型的条件致病菌,既可侵染植物,也能引起人类和动物的机会性感染。
在人工培养基上(如PDA)生长迅速,菌落初呈灰褐至深褐色,绒毛状或丝绒状,背面常呈黑色。显微镜下可见分生孢子梗单生或成束,从菌丝侧生,颜色深褐,顶端产生分生孢子。分生孢子深褐色,具3个横隔,通常由4个细胞组成,中间细胞体积明显膨大,颜色较深,使孢子整体呈弯曲或“新月形”外观,是本菌的典型特征。
Curvularia lunata 具有较强的环境适应性,可在温暖潮湿条件下迅速繁殖。它是多种植物(如玉米、水稻、草类植物)的病原真菌之一,能引起叶斑病、穗腐病等。同时,该菌在免疫力低下人群中偶可导致角膜炎、鼻窦炎或肺部感染等机会性感染,因此在临床真菌学中也具有一定的关注价值。